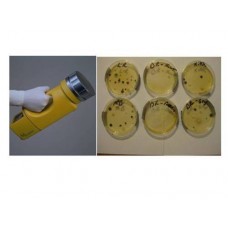
Air Sampling Test Service

Aero Biotechnique
Get Quote
8303 Handheld Particle Counter
8303 Handheld Particle CounterProduct Details :The Particles Plus 8303 Handheld Particle Counter mea..
₹0
8306 Handheld Particle Counter
8306 Handheld Particle CounterProduct Details :The Particles Plus 8306 Handheld Particle Counter mea..
₹0
Acrylic Manometer
Acrylic ManometerProduct Details:Measuring Range10 mm wg to 200 mm wgTechnical Specifications:Manome..
₹0
Aero Biotech Biological Air Sampler
Aero Biotech Biological Air SamplerProduct Details :Atmosphieric Pressure80-120 kpaBiological Air Sa..
₹0
Aero Biotech Particle Counter
Aero Biotech Particle CounterProduct Details:ApplicationIndustrialAero Biotech Particle counter..
₹0
Aerosol Generator
Aerosol GeneratorSpecification:-Size: 11" (L) x 11" (W) x 10" (H) 11" (L) x 8" (W) x 10" (H)Weight: ..
₹0
Aerosol Mass Monitor
Aerosol Mass MonitorProduct Details :BrandAero biotechniquesWe are Manufacturer and Supplier of prem..
₹0
Aerosol Photometer
Aerosol PhotometerProduct Details :The TDA-2E is a completely self contained near forward light scat..
₹0
AHU Recovery Test Service
AHU Recovery Test ServiceProduct Details :The time taken for an AHU of a clean room to maintain back..
₹0
Air Capture Hood
Air Capture HoodProduct Details:Dimensions120*300 mmWith the aid of experts, we present a wide range..
₹0
Air Conditioning Filters
Air Conditioning FiltersProduct Details :Our filters are highly efficient in attracting the dust, po..
₹0
Air Pattern Test Service
Air Pattern Test ServiceProduct Details:Application/UsageChemical IndustryAMC RequiredYesValidation ..
₹0
Air Purifier
Air PurifierProduct Details:Automatic GradeAutomaticColorBlackConditionNewOur firm is among the trus..
₹0
Air Purifier For Car
Air Purifier For CarProduct Details :UsageCarKeeping in mind the exact demands of patrons, we offer ..
₹0
Air Quality Monitor
Air Quality MonitorProduct Details:ModelABT-DM03ApplicationHOUSE HOLD, Industrial Use, Laboratory Us..
₹0
Air Quality Monitor
Air Quality MonitorProduct Details :The Particles Plus 5301-AQM and 5301-AQM Air Quality Monitor mea..
₹0
Air Quality Monitor
Air Quality MonitorProduct Details :The Particles Plus AQM Series Remote Particle Counter and Enviro..
₹0
Air Sampler
Air SamplerProduct Details:Dimension168 (W) x 80 (H) x 35 (D) mmBiological Air Sampler is a kind of ..
₹0
Air Sampling Test Service
Air Sampling Test ServiceProduct Details :Air testing for specific chemical compounds is an investig..
₹0